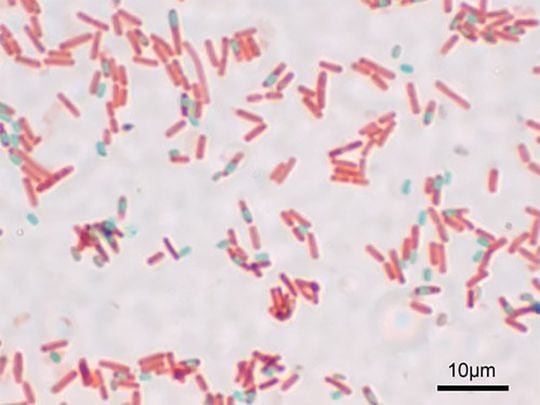
枯草菌(こそうきん、Bacillus subtilis)

微生物から食品を守るのは作り手の役割
そもそも、日本で使用されている添加物は、厚生労働省や内閣府食品安全委員会がリスク評価をしたうえで、ルールを守って正しく使えば安全、と認めたものです。
食品でもっとも気をつけなければならないのは、微生物の食中毒。保存料や日持ち向上剤などの添加物は、微生物の増殖を抑える効果は一定ありますが、殺菌までは望めません。したがって、添加物を使っていようがいまいが、微生物の混入付着や増殖は阻止しなければならない、というのが食品の衛生管理の基本です。問題の店はこれに失敗したようです。
プロ向けのパン作りの書籍を何冊も出版し、業界ではだれもが知るパン職人、竹谷光司さんに、この店のInstagramや客がXに投稿した「マフィンが糸を引く動画」などを見てもらいました。すると、瞬時に「これはロープ現象だね」という返事。竹谷さんは、ドイツでパン作りを修業し、帰国後は、製粉企業で小麦粉や製粉等の研究に携わりながら多数のパン職人を指導しました。定年退職後は千葉県佐倉市にパン工房をオープンし店頭で接客もし、他店のコンサルティングも手掛けています。
糸を引くのは細菌による「ロープ現象」
ロープ現象というのは、パンや焼き菓子で細菌が増殖し腐敗し、糸を引くようになること。原因はBacillus(バシラス)属の細菌です。自然界によくいる菌で、枯草菌や納豆菌もこの仲間。マフィンの原材料の小麦粉や生のフルーツなどにもいます。これらの中には、「芽胞」を作って耐熱性を持ちオーブンで焼かれても生き残るタイプがいて、温度が下がると発芽し生温かな状態が続くと一気に増殖します。
また、土付きの野菜やフルーツ、じゃがいもなどの調理場への持ち込みによりバシラス属の細菌が調理場に住み着いてしまうことも。消毒しても完全に殺菌するのは難しく、調理場の菌が食品に付き増殖することがあります。
こうしてパンや焼き菓子でバシラス属の細菌が増殖し、糸を引くのです。竹谷さんによれば、20年ほど前までは、原材料や調理場が細菌で汚染されていることがあり、時々ロープ現象を見たとのこと。
その後、製粉企業や原材料メーカーの管理レベルが格段に向上し小麦粉などに含まれる細菌が減ったことや、土付きの野菜やじゃがいもなどの調理場への持ち込みが危険であることが周知されたことなどもあり、めったに見なくなったそうです。くだんのマフィンの動画に「久々に見たよ」というのが竹谷さんの第一声でした。